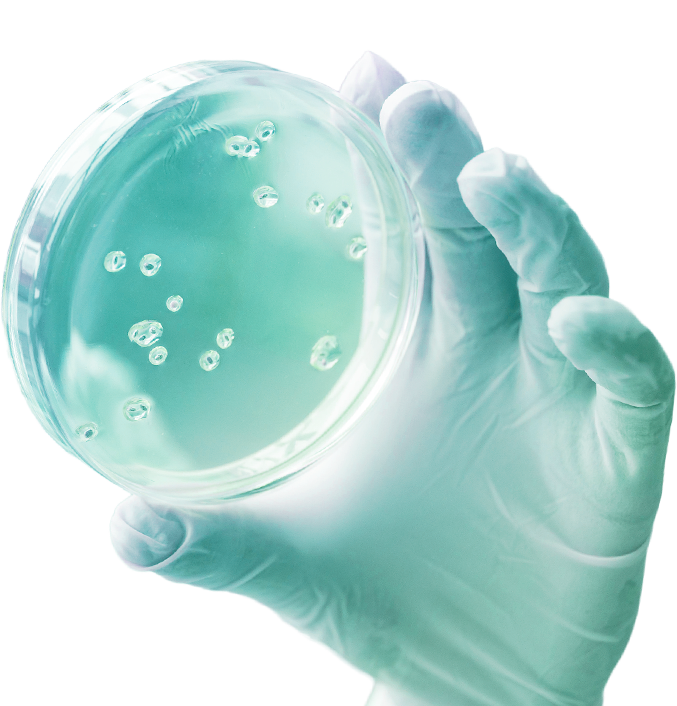

07 a 10 Maio
XIII
Simpósio
Instituto de Ciências Biológicas (IB)
Campus Universitário Darcy Ribeiro Universidade de Brasília
Programação
07/12
Tema: Imunologia – Terapia, Vacinas e Interação patógeno hospedeiro08:30 – 09:15
Registro dos participantes
Entrega de material
09:15 – 09:30
Abertura
09:30 – 10:25
Palestra de abertura
Prof. Martin Bonamino — INCA e Fiocruz do Ceará
Desenvolvimento de Terapias com Linfócitos Geneticamente Modificados
10:25 – 11:10
Palestra
Profª. Fátima Ribeiro Dias — Universidade Federal de Goiás
Polimorfismos nos genes da via da vitamina D: resistência e suscetibilidade à leishmaniose tegumentar americana.
11:10 – 11:25
Coffee Break
11:25 – 12:10
Palestra
Helton da Costa Santiago — Universidade Federal de Minas Gerais
Desenvolvimento Clínico da SpiN-Tec: uma vacina brasileira contra Covid-19
12:10
Almoço
14:00 – 17:00
Sessão de Pôsteres
08/12
Tema: Genômica, Biologia Estrutural e IA aplicada à Química Medicinal09:00 – 10:30
Mesa Redonda
Biologia estrutural e Química medicinal
Aisel Valle Garay — Pesquisador Colaborador PPGBiomol – IB-UnB
Uma jornada de 30 minutos pelas raízes históricas centenária da Ultracentrifugação Analítica e suas perspectivas atuais para sua compreensão científica e tecnológica
Prof. Bruno Neves — Universidade Federal de Goiás
Improving Drug Discovery and Toxicity Assessment with Multitask Learning: An Artificial Intelligence Approach
Brenno Amaro da Silveira Neto — Instituto de Química – UnB
Bioimageamento com sistemas fluorescentes: sintetizado na Química, aplicado na Biologia
10:30 – 10:45
Coffee Break
10:45 – 11:30
Palestra
Prof. Dario Grattapaglia — Embrapa-DF
Genômica e genética quantitativa convergem para a predição de características complexas: Fisher já sabia de tudo 100 anos atrás
11:30 – 11:50
Workshop BS Diagnóstica
Técnicas de Biologia Molecular – Aplicações e Inovações
Apoiadores






Comissão organizadora
- Bruna Rafaela Bezerra Gomes – Pos doutorado
- Daniel Neves – Mestrando
- Izabela Marques Dourado Bastos Charneau – Professora IB – UnB
- Izadora Cristina Moreira de Oliveira – Pos doutorado
- Lucas Oliveira – Pos doutorado
- Luísa Valério Franca- Mestranda
- Paula Beatriz – Pos doutorado
- Raquel Almeida – Pos doutorado
- Samyra Espíndola Lima – Doutoranda